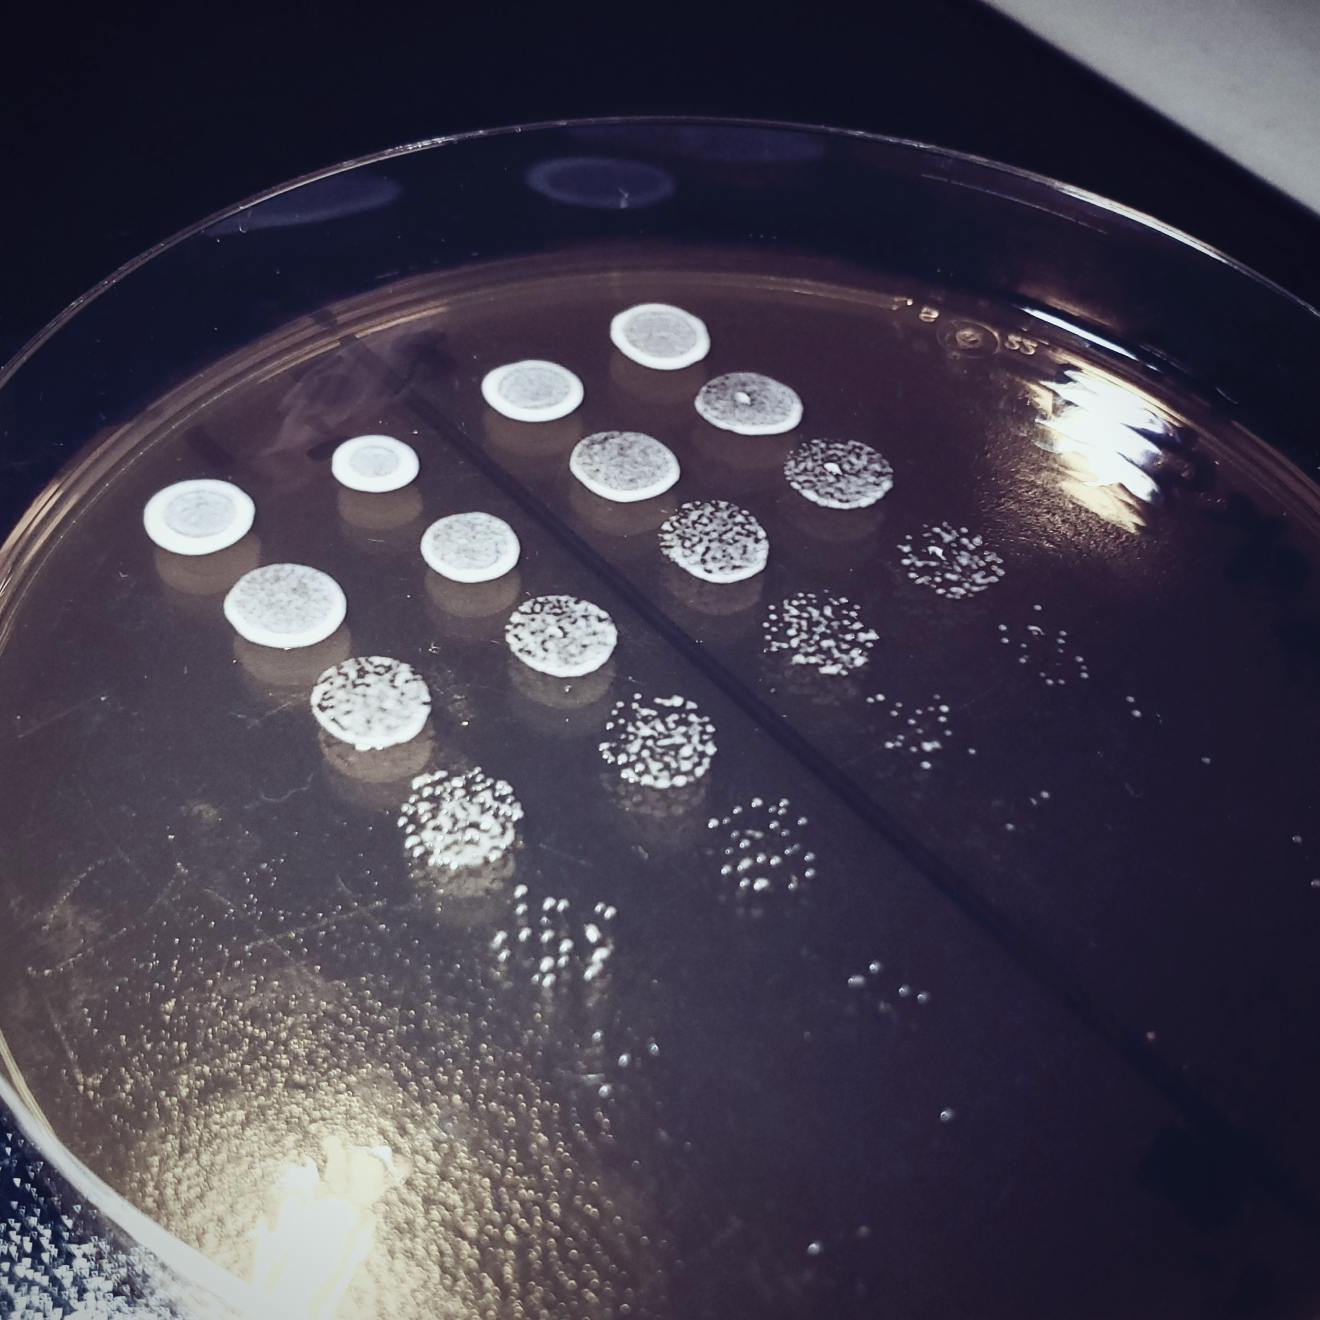

Download the step-by-step Imio Product Guide
Indole-3-acetic acid (IAA) is a rooting and plant growth hormone naturally produced by plants and certain microbes.
Popular rooting gels replicate this hormone with a synthetically derived version, 1-Napthaleneacetic acid (NAA). These compounds differ slightly as shown in the diagram to the left, resulting in less effective plant interactions.
Synthetic rooting products impact humans as well due to carcinogenic and mutagenic components.
Sources: Oregon State Extension; Flasińki et al 2014
Imio Root


Experiments by Dr. Deborah Neher, 14 year Chair of Department of Plant and Soil Sciences. Comparison of four prototype versions of Imio's Re-Gen vs the prior state of the art microbial inoculant for organics recycling showed Imio's Re-Gen offers superior eco-enzyme production and plant outcomes.

What is IMIO Re-Gen?
Re-Gen recaptures nutrient value from crop residue, breaking it down to feed the next crop. It’s a combination of fungi, bacteria, and yeast, shipped as a freeze dried powder to provide best in class microbial activity at application. We guarantee 100,000x higher CFUs vs other biological products.
Why would microbes help my plants?
Plants and microbes have evolved alongside one another for thousands of years. Beneficial microbes help break down organic matter, release nutrients, suppress disease, and promote root development.
What crops can I use Re-Gen on?
Re-Gen has been validated on corn, soybeans, wheat, rye straw, hay crops, and specialty crops such as hops, lettuce, broccoli, melons, and cannabis crop residues. It is best used in fields with high residue from the previous crop, and significant nutrient demand for the upcoming crop.
What kind of results can I expect?
In field trials, spring applications of Re-Gen have shown yield increases of up to 20 bushels per acre, even under extreme weather conditions.
How much nutrient value does Re-Gen unlock?
On average, Re-Gen helps unlock approximately:
...from every acre of corn stover. That’s a recaptured nutrient value of about $218/acre.
How does Re-Gen compare to composting?
Re-Gen works faster (2–4 weeks vs. 12+ months), delivers better plant growth (up to 40% larger plants vs. premium compost), and ensures more targeted breakdown of residue through specially selected microbes. It directly introduces the right microbes to recycle crop residue, where composting indirectly tries to cultivate the right microbial populations.
What microbes are in Re-Gen?
Re-Gen contains:
Are IMIO products safe?
Yes. All microbes used are naturally occurring and Generally Recognized as Safe (GRAS) by the FDA. We exclude any strains flagged by research as potentially harmful.
How long does Re-Gen last before and after mixing?
What’s the application rate?
Can I use Re-Gen with my current tank mix?
Yes, but follow these guidelines:
For more information, see our mixing guide.
What kind of water should I use?
Can I apply with a drone?
Yes. Re-Gen’s high concentration makes it ideal for drone application. Just ensure it lands on as much residue as possible to maximize decomposition.
Do I need to clean my sprayer?
Yes. Like any biological product, Re-Gen should not sit idle in spray lines. Rinse your equipment after application to prevent microbial buildup.
How is Re-Gen manufactured?
Each microbial strain is grown and tested individually, then combined in precise ratios. This ensures every batch delivers consistent performance and shelf life.
Is Root the same as other cloning gels?
No. Root uses naturally occurring microbes that stimulate the plant’s own hormone production (e.g., IAA), unlike synthetic gels that contain artificial hormones like NAA, which can be carcinogenic and less effective.

See how farms are using IMIO